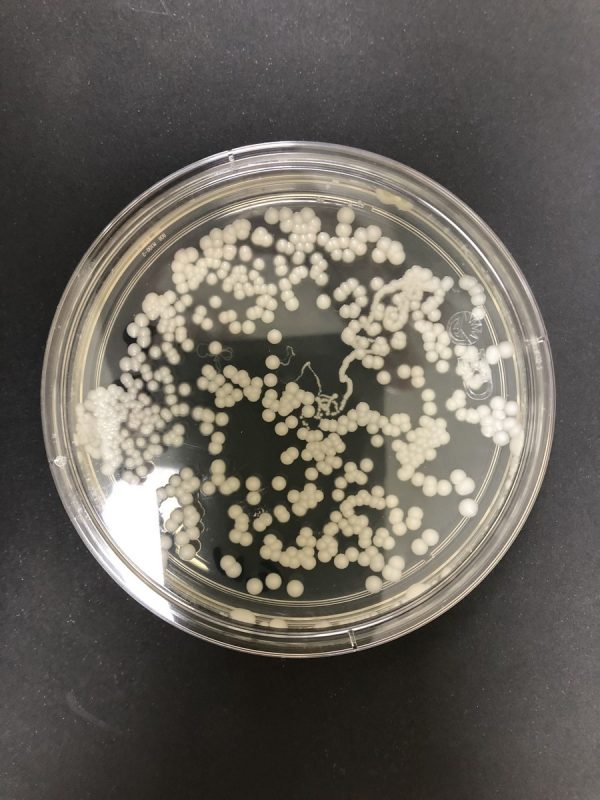

NUESTRA MISIÓN
Ofertar a nuestros clientes servicios de consultoría en microbiología y biotecnología para el desarrollo de estrategias efectivas para la mejora continua en sus procesos con fundamento en el conocimiento científico-tecnológico, la innovación y la sustentabilidad.
QUIENES SOMOS
Somos una empresa que inicia labores en 2018 y que está dedicada a la consultoría especializada en microbiología y biotecnología aplicada para las industrias agrícola, pecuaria, alimentaria en industrial.
NUESTRA VISIÓN
Ser un empresa líder en consultoría en Microbiología y biotecnología en el ámbito de las industrias agrícola, pecuaria, alimentaria e industrial, generar aportes a la innovación científico tecnológica, estar altamente vinculado a las necesidades de nuestros clientes, su entorno social y ambiental así como contribuir a la mejora de procesos y consolidarse como punto de referencia en el diseño y desarrollo de estrategias y evaluación de los diferentes procesos en las áreas de la industria alimentaria y agropecuaria entre otras.